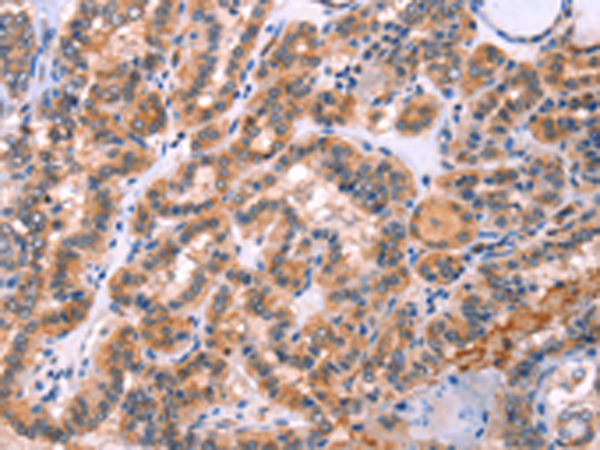
一抗

|
Background: |
This gene encodes a member of the STXBP/unc-18/SEC1 family. The encoded protein is involved in intracellular trafficking, control of SNARE (soluble NSF attachment protein receptor) complex assembly, and the release of cytotoxic granules by natural killer cells. Mutations in this gene are associated with familial hemophagocytic lymphohistiocytosis. Alternatively spliced transcript variants encoding different isoforms have been noted for this gene. |
|
Applications: |
ELISA, IHC |
|
Name of antibody: |
STXBP2 |
|
Immunogen: |
Fusion protein of human STXBP2 |
|
Full name: |
syntaxin binding protein 2 |
|
Synonyms: |
FHL5; UNC18B; Hunc18b; UNC18-2; pp10122; MUNC18-2 |
|
SwissProt: |
Q15833 |
|
ELISA Recommended dilution: |
2000-5000 |
|
IHC positive control: |
Human thyroid cancer and human liver cancer |
|
IHC Recommend dilution: |
25-100 |

 購物車
購物車 幫助
幫助
 021-54845833/15800441009
021-54845833/15800441009